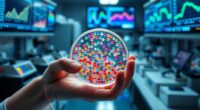
resampling for data uncertainty

Bayesian inference uses advanced methods to update your statistical models as new data arrives, making your guesses more accurate over time. By combining prior beliefs with evidence, it provides a flexible framework for dynamic decision-making. Techniques like Markov chains help model evolving processes where current beliefs depend only on the previous state. Continuing with these concepts can deepen your understanding of how to refine models effectively in complex, real-world scenarios.
Key Takeaways
- Advanced Bayesian methods include hierarchical modeling, which captures complex data structures and dependencies across multiple levels.
- Markov Chain Monte Carlo (MCMC) techniques enable efficient sampling from complex posterior distributions in high-dimensional models.
- Variational inference offers scalable approximations for Bayesian inference, suitable for large datasets and real-time applications.
- Bayesian model selection and averaging facilitate robust decision-making by comparing multiple models and incorporating model uncertainty.
- Sequential Bayesian updating, leveraging Markov chains, allows dynamic incorporation of new data, maintaining adaptable and coherent statistical models.

Have you ever wondered how statisticians update their beliefs in light of new evidence? It’s a fascinating process rooted in the concept of prior updates, where initial assumptions or beliefs are adjusted as fresh data becomes available. Bayesian inference provides a systematic way to do this, allowing you to refine your understanding over time. At its core, it involves starting with a prior probability—a subjective or data-driven belief about a parameter or hypothesis. When new data arrives, you don’t simply discard your prior; instead, you incorporate this evidence to produce a posterior distribution, which combines both the prior and the likelihood of the new data. This iterative process ensures your beliefs evolve naturally, reflecting the most current information.
To model how these updates occur over sequences of data, statisticians often turn to Markov chains. Markov chains help describe systems where the present state depends only on the immediate past, not on the entire history. In Bayesian contexts, this means that your belief at one point depends solely on the previous belief and the latest evidence, making the process computationally manageable. When combined with prior updates, Markov chains enable you to perform sequential Bayesian inference efficiently. For example, as you observe a series of outcomes, the posterior distribution from one step becomes the prior for the next. This dynamic updating aligns perfectly with real-world scenarios where data streams in continuously, and decisions need to adapt accordingly.
Using Markov chains for prior updates also introduces a powerful conceptual framework. It allows you to model complex, stochastic processes where the state of knowledge evolves over time. Whether you’re tracking the probability of a machine’s failure, predicting stock market trends, or updating disease prevalence estimates, Markov chains facilitate a structured approach to handling uncertainty. They help ensure your model remains consistent with the Markov property, meaning your current belief depends only on the immediate previous state, simplifying calculations and enhancing interpretability.
Frequently Asked Questions
How Does Bayesian Inference Compare to Frequentist Methods?
You’ll find Bayesian inference offers greater model flexibility, allowing you to incorporate prior knowledge and update beliefs with new data. Unlike frequentist methods, which focus on long-run frequencies, Bayesian approaches provide direct probability statements about parameters. However, you might encounter interpretability issues, especially with complex models. Overall, Bayesian methods give you a more nuanced understanding, but they can be computationally intensive and harder to interpret initially.
What Are Common Challenges in Implementing Bayesian Models?
Implementing Bayesian models can be a daunting task; it’s like steering through a complex maze! You’ll face challenges like computational complexity, which demands powerful algorithms and significant resources. Prior selection can also be tricky, as choosing inappropriate priors skews results. Balancing these issues requires careful planning, expertise, and sometimes creative problem-solving to guarantee your model is both accurate and efficient.
How Do Priors Influence Bayesian Inference Outcomes?
You should understand that priors greatly influence Bayesian inference outcomes, especially through prior sensitivity. If your priors are too strong or biased, they can skew results, so it’s vital to examine prior predictive checks to see how your chosen priors impact the model’s predictions. Carefully selecting and testing your priors helps ensure your inferences are robust and not overly dependent on subjective assumptions.
Can Bayesian Methods Be Applied to Real-Time Data Analysis?
Yes, you can apply Bayesian methods to real-time data analysis. They excel at handling dynamic data because you can update your model continuously as new information arrives. This process, called model updating, allows you to refine your estimates and predictions on the fly. By incorporating incoming data into your priors and likelihoods, you maintain an adaptive analysis that responds quickly to changing conditions.
What Software Tools Are Best for Advanced Bayesian Modeling?
You should consider software tools like Stan, PyMC, and JAGS for advanced Bayesian modeling. These tools offer robust modeling frameworks and strong community support. Stan excels with its efficient Hamiltonian Monte Carlo algorithms, while PyMC provides a user-friendly Python interface. JAGS is great for hierarchical models. Comparing their features and performance helps you choose the best software for your complex Bayesian analysis needs.
Conclusion
While Bayesian inference offers profound insights and elegant solutions, it’s not without its subtle complexities. Embracing its nuanced methods can gently guide you through intricate data landscapes, revealing patterns that might otherwise remain hidden. With patience and care, this approach can enrich your understanding, gently steering your models toward greater accuracy. Ultimately, it’s a sophisticated dance with uncertainty—one that rewards those willing to navigate its delicate, yet rewarding, terrain.